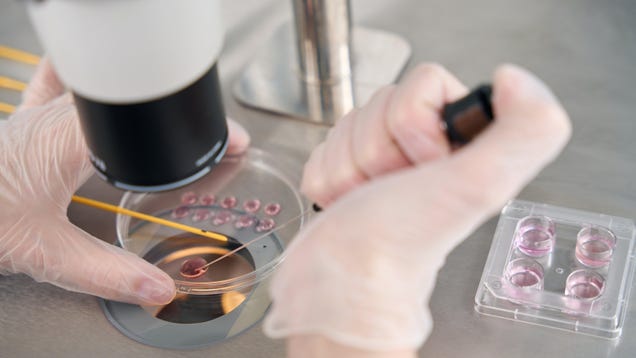

A team of scientists in Israel say they’ve accomplished an incredible feat of biology: The creation of a completely human-like embryo model without the need for a sperm or egg. The synthetic embryos were grown using stem cells instead and appeared to have the same structures and components of a typical human embryo up…
Source: Gizmodo – Scientists Say They’ve Now Grown a Whole Human Embryo Model From Scratch